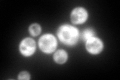
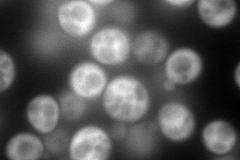
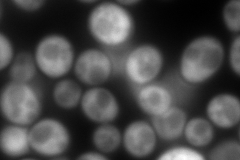
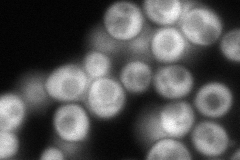
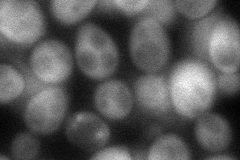
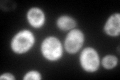

View description
Protein that binds tRNA and methionyl- and glutamyl-tRNA synthetases (Mes1p and Gus1p), delivering tRNA to them, stimulating catalysis, and ensuring their localization to the cytoplasm; also binds quadruplex nucleic acids
Localization:
Intensity:
Fold change:
Significance:
-
C’ GFP library in SD
cytosol293.06 -
N' NOP1pr-GFP in SD
cytosol333.766 -
N' TEF2pr-mCherry in SD
cytosol489.874 -
N' NATIVEpr-GFP in SD
cytosol171.84 -
N' TEF2pr-VC and Cyto-VN in SD
cytosol81.3028 -
C’ GFP library in SD+DTT

cytosol275.250.93No -
C’ GFP library in SD+H2O2

cytosol311.991.06No -
C’ GFP library in Starvation Media
cytosol451.361.54Yes -
C’ GFP library on the background of Pup2-DaMP

cytosol -
C’ GFP library on the background of CCT mutant

cytosol266.7080.910061No
